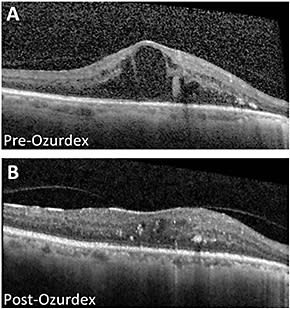

Managing the Complex Pathology of Diabetic Macular Edema
Case #1: Severe bilateral nonproliferative diabetic retinopathy and clinically significant DME.
By Bozho Todorich, MD, PhD, Yoshihiro Yonekawa, MD, and Kimberly A. Drenser, MD, PhD
Diabetic macular edema (DME) is a multifactorial disease in which a number of angiogenic, vascular, and inflammatory processes converge to produce characteristic macular changes observed in DME. Anti-VEGF agents (bevacizumab, Avastin, Genentech; ranibizumab, Lucentis, Genentech; and aflibercept, Eylea, Regeneron) are all effective treatment options for DME, and, in general, have been used as first-line agents for treatment of center-involving DME.1,2 However, the mechanism of action of these agents is directed toward only a single component of DME’s complex pathology, and as many as 50% of patients with DME will show partial or no response to anti-VEGF agents.3 For those patients, intravitreal steroids offer an effective alternative, producing simultaneous anti-inflammatory, antiangiogenic, and antivascular permeability effects.
One example in this class is the dexamethasone intravitreal implant (Ozurdex, Allergan), which is approved by FDA for the treatment of DME, cystoid macular edema associated with retinal vein occlusion, and noninfectious posterior uveitis.4 Ozurdex is an injectable biopolymer, which gradually disintegrates into water and carbon dioxide while delivering dexamethasone into the vitreous cavity over a period of several months.5 In our clinical experience, Ozurdex offers a viable alternative for patients with DME who demonstrate insufficient response to anti-VEGF therapy, as in the following case.
Case Report
A 57-year-old woman with uncontrolled type 2 diabetes has severe nonproliferative diabetic retinopathy in both eyes and clinically significant DME in her right eye. She is pseudophakic. Prior to referral to our practice, the patient was treated with focal laser and anti-VEGF therapy but presented with recurrent center-involving macular edema.
At the patient’s initial visit with us, she received intravitreal Lucentis. At 1 month post treatment, she showed no improvement in vision and minimal anatomic response on OCT (Figure 1). After a discussion of treatment options, the patient opted for treatment with Ozurdex (Figure 2). Two months post treatment, the patient’s best-corrected visual acuity (BCVA) had improved from 20/70 to 20/50. Central foveal thickness was significantly reduced, and intraretinal cystic changes on OCT were nearly resolved (Figure 2). There was no IOP elevation nor were there other adverse effects related to the steroid. The patient is now maintained on Ozurdex every 3 to 4 months with preservation of BCVA and excellent control of the DME.

Figure 1. One month after treatment with Lucentis, the patient showed no improvement in vision and minimal anatomic response.
Figure 2. After treatment with Ozurdex, there was a dramatic resolution of the intraretinal fluid and improvement in vision from 20/70 to 20/50.
Discussion
We commonly use Ozurdex to treat patients with DME who demonstrate suboptimal response to anti-VEGF therapy, as was the case with this patient. In our experience with patients with refractory DME, those controlled with Ozurdex have clinically meaningful control of their disease for 3 to 4 months, but they may require retreatment beyond that.
We have found that patients who do not demonstrate a reduction in central macular thickness by at least 25% after their first anti-VEGF treatment will likely be poor responders even after multiple subsequent injections.6 In our study, these patients responded well when switched to Ozurdex.
When considering a corticosteroid, we counsel all phakic patients about the risk of cataract progression, and we counsel all patients about potential IOP elevation. For those who develop ocular hypertension, the IOP elevation is often mild and can be controlled with topical medication. These patients rarely require a consultation with a glaucoma specialist or incisional glaucoma surgery. Ozurdex has become an important tool in our combat arsenal against DME.
Summary
When DME demonstrates suboptimal response to anti-VEGF therapy, Ozurdex is an important option to discuss with our patients. ■
References
1. Nguyen QD, Brown DM, Marcus DM, et al; RISE and RIDE Research Group. Ranibizumab for diabetic macular edema: results from 2 phase III randomized trials: RISE and RIDE. Ophthalmology. 2012;119:789-801.
2. Wells JA, Glassman AR, Ayala AR, et al; Diabetic Retinopathy Clinical Research Network. Aflibercept, bevacizumab, or ranibizumab for diabetic macular edema. N Engl J Med. 2015;372:1193-1203.
3. Elman MJ, Bressler NM, Qin H, et al; Diabetic Retinopathy Clinical Research Network. Expanded 2-year follow-up of ranibizumab plus prompt or deferred laser or triamcinolone plus prompt laser for diabetic macular edema. Ophthalmology. 2011;118:609-614.
4. Boyer DS, Yoon YH, Belfort R, Jr., et al; Ozurdex MEAD Study Group. Three-year, randomized, sham-controlled trial of dexamethasone intravitreal implant in patients with diabetic macular edema. Ophthalmology. 2014;121:1904-1914.
5. Cabrera M, Yeh S, Albini TA. Sustained-release corticosteroid options. J Ophthalmol. 2014;2014:164692.
6. Wolfe JD, Shah AR, Yonekawa Y, et al. Receiver operating characteristic curve to predict anti-VEGF resistance in retinal vein occlusions and efficacy of Ozurdex. Eur J Ophthalmol. E-pub October 2015.

| Bozho Todorich, MD, PhD |

| Yoshihiro Yonekawa, MD |

| Kimberly A. Drenser, MD, PhD |
Bozho Todorich, MD, PhD, Yoshihiro Yonekawa, MD, and Kimberly A. Drenser, MD, PhD, practice at Associated Retinal Consultants, Oakland University William Beaumont School of Medicine, Royal Oak, Mich. Dr. Todorich and Dr. Yonekawa have no financial disclosures. Dr. Drenser is a consultant to Allergan and a member of its speakers bureau. Dr. Drenser can be reached at kdrenser@arcpc.net. |








